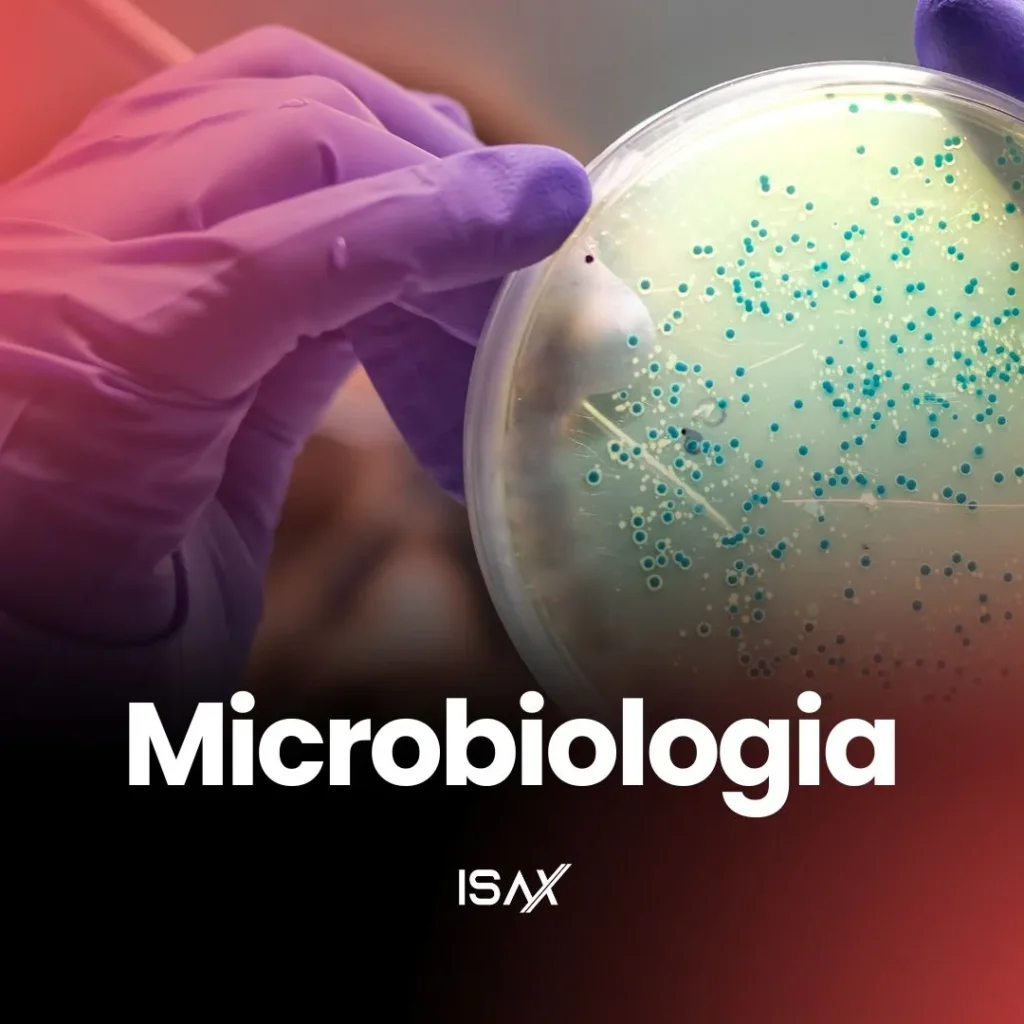

Área de Laboratório
Especialização com foco na prática jamais vista em Brasília. São 4 opções de estágios em laboratórios renomados!
Especializações para profissionais de Biomedicina, Biologia e Farmácia.
Didática aprovada e Comprovada por nossas alunas!
A área da saúde necessita de domínio, pois estamos lidando com vidas! Em nossas pós-graduações focamos no que realmente importa, A PRÁTICA. Por isso somos a única instituição em Brasília que oferece 4 opções de estágios em laboratórios renomados, tudo com o objetivo de formar profissionais 100% capacitados!
Atendimento no WhatsApp
Mande uma mensagem e receba em seu telefone: e-books, preços, formas de pagamento e muito mais!